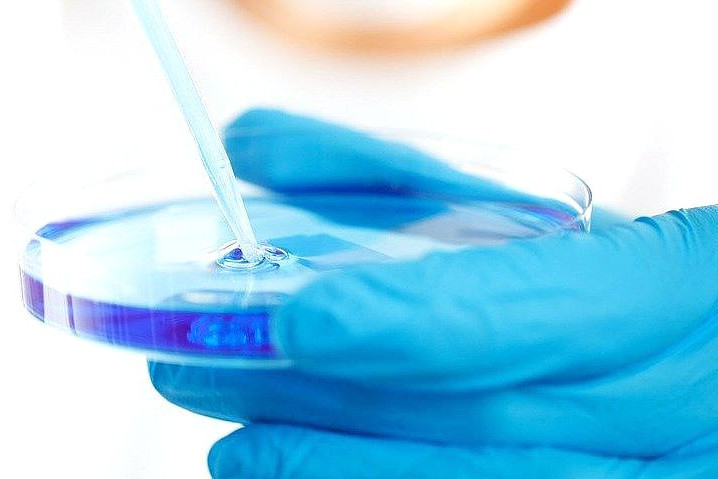

На создание регистра доноров костного мозга планируется выделить 3 млрд рублей
Госдума на пленарном заседании 19 апреля одобрила во втором чтении правительственный законопроект, распространяющий нормы закона о трансплантации органов на костный мозг и гемопоэтические стволовые клетки. В окончательном, третьем чтении документ планируется принять 20 апреля.
Согласно поправкам в закон «О трансплантации органов и (или) тканей человека», пересадка органов и тканей человека, в том числе костного мозга и гемопоэтических стволовых клеток, допускается при наличии письменного добровольного согласия совершеннолетнего дееспособного живого донора и реципиента. Если реципиент несовершеннолетний или недееспособный, письменное согласие должен предоставить его родитель или законный представитель.
Уточняется, что органы или ткани человека не могут быть предметом купли-продажи.
Изъятие органов или тканей для трансплантации у умершего запрещается, если медицинская организация поставлена в известность о том, что при жизни человек или его представители заявили о несогласии на изъятие.
Кроме этого, живой донор, давший добровольное согласие на изъятие своих органов или тканей, включая костный мозг и гемопоэтические стволовые клетки, для пересадки, наделяется правом на медицинское обследование, лечение и реабилитацию, на ознакомление с результатами его обследования, оплату проезда к месту забора костного мозга и гемопоэтических стволовых клеток и обратно в порядке, установленном Правительством РФ.
Законопроект предусматривает создание федерального регистра доноров костного мозга и гемопоэтических стволовых клеток, самих донорских органов и их реципиентов. Правила ведения регистра ранее утвердило правительство, его оператором назначено Федеральное медико-биологическое агентство (ФМБА) России, сообщал «МВ».
| Согласно финансово-экономическому обоснованию, на реализацию законопроекта потребуется 2,909 млрд руб. на период 2021–2023 годов. Основная часть расходов предусмотрена на типирование главного комплекса гистосовместимости новых доноров для включения в регистр – 1,656 млрд руб. (ежегодно по 552 млн руб.). На забор, переработку, хранение, транспортировку и обеспечение безопасности костного мозга и гемопоэтических стволовых клеток в целях их трансплантации потребуется 914,767 млн руб., на медицинское обследование потенциальных доноров – 162,256 млн руб. Кроме того, на обеспечение расходов на проезд доноров к месту проведения забора и обратно запланировано 33 млн руб., на информирование населения о социальной значимости костного мозга и гемопоэтических стволовых клеток – по 12 млн руб. ежегодно. |
Комитет Госдумы по охране здоровья ко второму чтению одобрил поправки в законопроект, согласно которым гражданин, намеревающийся стать донором костного мозга или гемопоэтических стволовых клеток, имеет право на бесплатное медицинское обследование для включения в федеральный регистр доноров. Уточняется также, что такие доноры имеют право на бесплатный проезд к месту изъятия органов и обратно за счет бюджетных ассигнований.














Нет комментариев
Комментариев: